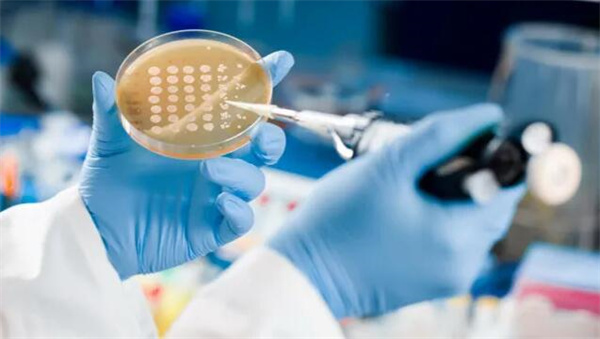
QQ截圖20211101213310.jpg

今天說起香港作為國際金融中心的亮點之一,一定少不了每年在全球名列前茅的IPO的集資規模總額。
而最新全球IPO市場規模排名方面,澳洲卻成為了一匹黑馬,其10月的IPO交易規模竟然超越香港,為兩年多來首次罕見!
澳洲10月錄IPO交易規模單月最高
數據顯示,10月,透過IPO在澳洲市場募資的公司數量為20家,籌集資金總計35億美元,這一數字為2014年11月以來,澳洲單月表現的最高規模。
至於為什麼會超越香港,而是同期內,香港的IPO交易錄得3宗,規模為7.32億美元,剛好是去年4月以來的單月最低水平。
根據田忌賽馬原理,當澳洲的單月最佳表現適逢香港錄得單月最低表現,那被超越或許也毋須太過緊張。
不過,業內人士認為,澳洲在IPO規模方面的強勁表現有機會持續,理由是第四季度為澳洲IPO的最繁忙時段,同時亦有幾宗大型交易在推進之中,其中就包括了建設服務提供商Ventia Services Group Pt的融資需求,光是這一單的融資需求便或將高達9億美元。此外,澳洲開放邊境的政策或許亦有利於其商業環境及經濟的復蘇。

(近來,內地對科技、地產及教育行業收緊監管。)
至於香港為何上個月IPO交易規模會成為去年4月來的單月最低,有消息認為同內地對科技、地產及教育行業的監管收緊有關,港交所自7月初便幾乎未有任何大型的IPO動態資訊。
港交所前三季IPO表現依然強勁
就在四日前,港交所最新公布了今年第三季度的財報數據,據悉,今年前三季度,港交所營業收入錄得162.18億港元,按年上升15%;股東應佔溢利98.61億港元,按年增15%,期內營收和盈利均創歷年來最高紀錄,如此亮眼的數據可謂是逆勢而上。
此外,本港IPO情況于今年前三季度繼續表現強勁,今年前三季度,在港交所上市的公司數目有73家,集資額達到2859億元,刷新記錄。其中,醫療方面的IPO情況尤其保持活躍,共有23宗新上市,總集資額達579億元,按年增長37%。在目前新上市的73家公司中,還包括多宗大型雙重主要上市及生物科技股。
(今年以來,醫療方面的IPO情況尤其活躍。)
港交所行政總裁歐冠昇指出,截至今年第三季度結束,港交所仍有超過200家正在處理中的上市申請,為歷年來的較高水平,其中,包括50多家醫療健康公司,這亦反映香港作為“國際生物科技融資中心”的水平和吸引力與日俱增。
港交所歐冠昇:對未來上市新股數目樂觀
歐冠昇續指,儘管第三季度的新股招股上市雖然受到監管收緊消息等方面的影響,令投資市場猶疑而在投資態度上轉為保守,出現放緩情況。但相信港交所第三季度的上市公司數目和集資情況只是延續第二季度的走勢。
歐冠昇認為,相比去年第三及第四季度的情況,今年新股市場的情況難免會較具挑戰性,因此最佳的做法是將各季的表現合起來去計算。

(歐冠昇)
歐冠昇提示大家不要過度關注某個階段的數字,而是要整體全面計算,並且要看到港交所今年年初至今的IPO方面規模創新高的事實。
對於未來新股上市數目,歐冠昇亦持樂觀態度。
畢馬威料港全年募資達5000億
歐冠昇認為,目前新股上市無疑聚焦于主板市場,但創業板市場(GEM)方面,歐冠昇表示,無論如何依然會留意GEM的將來情況,將檢視GEM對上市公司及投資者的吸引力。
至於有市場認為港交所的SPAC(特殊收購目標公司)上市制度建議門檻過高,歐冠昇重申,期望引入的SPAC是高質素公司,並平衡投資者保障。有關諮詢將於本周結束,在評估所收集的市場意見后,會盡快公布諮詢結果。
市場相信,香港IPO市場依然活躍,其中畢馬威預測,香港2021年全年募資金額或將達到5000億港元,有機會創歷史新高。(歡醬)

